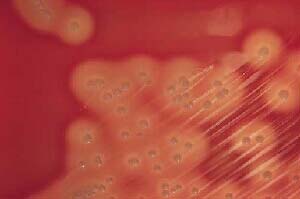

pdf ucretsiz indirin

macconkey agar

leishmania donovani promastigotes

moraxella enfeksiyonlar do dr arzu

researchgate

https tr questionofwill com 12101 pasteurella characteristics habitat culture media main species

ii sinif tibbi mikrobiyoloji
mikrobiyoloji org

ghkjuffztdcz4m

mikrobiyoloji laboratuvar

140 238 15 248

leishmania donovani promastigotes

gram pozitif sporsuz anaerob basiller

dr banu sancak

unite 5 mikroorganizmalarin uretildigi

bildiri ozetleri veteriner cerrahi

francisella enfeksiyonlar do dr arzu

besiyerleri ve tanitimlari mikrobiyoloji

d vitamini
You May Like